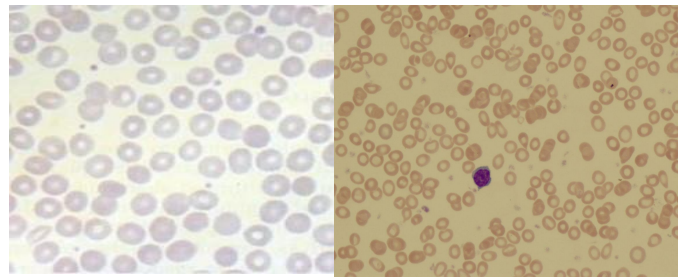
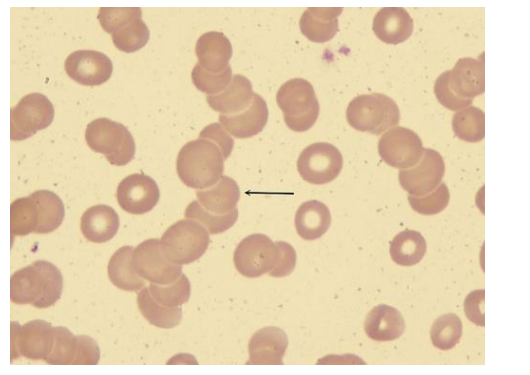
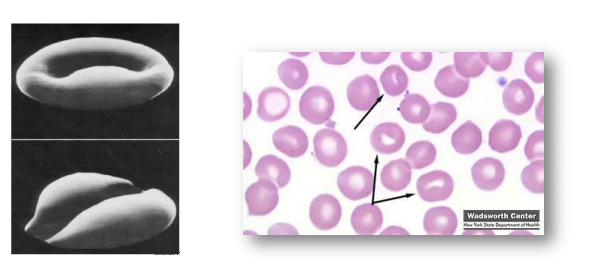

Alterações Morfológicas Eritrócitos
Noções Básicas em Auxiliar de Laboratório de Hematologia Clínica
1 Alterações Morfológicas Eritrócitos:

Eritrócitos
- Elemento sanguíneo figurado que apresenta forma circular e bicôncava sendo dotado de grande flexibilidade devido ao arranjo de sua membrana;
Elementos anucleados
- Permanecem exercendo sua função após perda do núcleo • Diâmetro variando entre 6 a 8µm;
- Vida em média de 120 dias;
- Hemocaterese realizada por macrófagos esplênico e hepático
- São os elementos mais abundantes encontrados na corrente sanguínea;
- 4,5 a 6 milhões/mm³ (♂);
- 4 a 5,5 milhões/mm³ (♀).
- Principal função;
-Transporte de gases – oxigênio e CO2
- O equilíbrio entre eritopoese e hemocaterese mantém aproximadamente 5 milhões/mm3 de eritrócitos;
- A contagem de reticulócito indica a atividade medular e a dosagem de urobilinogênio indica destruição do eritrócito.
2 Membrana do eritrócito:
Composta por 52% de proteínas, 40% lipídeos e 8% de carboidratos;
- Dupla camada de fosfolipídeo, intercalada por pontes colesterol e uma pequena quantidade de glicolipídeo (ceramida);
-Fosfolipídeos: fosfatidilcolina, fosfatidilserina, fosfatidiletanolamina, esfingomielina e lisofosfolipideo.
- Perdas de lipídeos são compensadas com a reposição via lipoproteinas, já que os eritrócitos não sintetizam lipídeos novos
- Elasticidade e viscosidade são características essenciais para deformação do eritrócito;
- Região externa;
-Presença de proteínas periféricas e glicolipídeos formadores dos antígenos eritrocitários.
- Região intramembrana;
-Presença de proteínas integrais ancoradas ao citoesqueleto
- Permeabilidade da membrana;
- Presença de canais proteicos dependente e independente de energia
- Permeabilidade a água e íons como HCO3- e Cl-.
- Canais dependentes de energia;
Bomba de Na+ e K+
Bomba de Ca2+
- Manutenção de níveis ideais de Ca2+ intracelular responsáveis pela manutenção da morfologia e flexibilidade “celular;
- Citoesqueleto;
- Formado por espectrina, anquirina e actina
- Responsáveis pela integridade e elasticidade da membrana
- Alterações no esqueleto proteico podem ocasionar hemólise
esferocitose.


3 Hipocromia:
Quando os eritrócitos possuem menos hemoglobina do que o esperado, eles se apresentam mais pálidos nos esfregaços sanguíneos, assim são chamados de hipocrômicos e a alteração, hipocromia. Em consequência à falta de hemoglobina, o eritrócito fica menor do que o normal da espécie, sendo chamado de micrócito e a alteração de microcitose. As anemias de características microcíticas hipocrômicas quase sempre são do tipo ferropriva.
4 Anisocitose:
Este termo se refere à presença de eritrócitos de tamanhos diferentes, o que acontece nas anemias regenerativas quando há células de tamanho normal, policromatófilos, e também micrócitos nas anemias ferroprivas.
5 Rouleaux e Hemoaglutinação:
O rouleaux e a hemoaglutinação não são alterações individuais e sim de grupos de eritrócitos, pois se referem à disposição destes nos esfregaço sanguíneo quando aparecem formando cadeias ou pilhas de células no rouleaux ou agrupamentos desorganizados na hemoaglutinação. Eles ocorrem quando a proteína plasmática total (PPT) está aumentada, tanto em processos inflamatórios, neoplásicos, infecções e até na gestação.
O rouleaux acelera a velocidade de hemossedimentação, que mede a capacidade dos eritrócitos se sedimentarem em um tubo de vidro durante determinado tempo; em humanos este parâmetro é bastante utilizado como indicador inespecífico de doenças, porém em animais sua utilização ainda é limitada. Em equinos, o rouleaux não é uma alteração e sim um achado normal, já a hemoaglutinação não é normal em nenhuma espécie; nos outros animais além de serem apontadas como alterações também podem ser classificadas de acordo com sua intensidade, em discreta, moderada e intensa, porém alguns autores consideram esta classificação um tanto subjetiva. Poiquilocitose
Quando no esfregaco sanguíneo estão presentes hemácias de formatos diferentes ou irregulares chamamos de poiquilocitose ou pecilocitose. Na verdade, o termo poiquilocitose é abrangente para diversas alterações de forma dos eritrócitos, como será visto no decorrer desta apostila.
6 Hemácias em Alvo:

Estes são eritrócitos nos quais houve concentração da hemoglobina na região central da célula, fazendo com que esta reproduza a forma de um alvo. Estas células são também chamadas de leptócitos, codócitos ou target cells, do termo target que quer dizer alvo em inglês. As hemácias em alvo são associadas à talassemia, estados homozigotos de disfunção da hemoglobina, situação não hemolíticas como icterícia obstrutiva, após esplenectomia, e em doenças hepáticas ou esplênicas crônicas. Alguns autores acreditam que estas células possuem excesso de membrana celular em relação à quantidade de hemoglobina em seu interior.
Excentrócitos:
Excentrócitos são eritrócitos que apresentam a hemoglobina concentrada em um de seus polos, apresentando o outro polo pálido após a coloração. Esta alteração de deve a oxidação da membrana celular do eritrócito.
Esferócitos:
Esferócitos são eritrócitos de forma esférica, que tem essa forma porque sofreram uma deformação de sua membrana citoplasmática devido a ação de anticorpos anti-eritrócitos. Os anticorpos anti-eritrócitos são produzidos na anemia hemolítica autoimune (AHAI) em seres humanos e cães, anemias hemolíticas causadas por drogas, anemia hemolítica do neonato e nos seres humanos, há também a esferocitose hereditária. No esfregaço além da forma esférica, os esferócitos são menores do que as células normais, coram-se intensamente e não apresentam a área de palidez central.
Hemácias-Fantasma:
As hemácias-fantasma ocorrem por processos de hemólise intravascular e também estão presentes nas anemias imunomediadas, como a AHAI, processos de intoxicação ou injúria aos eritrócitos. Nas lâminas aparecem como eritrócitos muito pálidos, como se fosse apenas uma sombra da célula.
Acantócitos ou Burr Cells:
Os acantócitos são eritrócitos de forma irregular, que podem ser vistos na forma de estrela. O termo burr vem do inglês que quer dizer serra circular e também denota a forma da membrana citoplasmática destas hemácias, que não deve ser confundida com artefatos de técnica. Os acantócitos estão presentes em doenças renais e esplênicas, hemangiossarcomas e, às vezes, na cirrose.
Crenação:
A crenação é considerada a alteração morfológica mais comum dos eritrócitos, no entanto, na maioria das vezes não se trata de uma alteração patológica e sim um artefato de técnica, geralmente causado pelo anticoagulante, o EDTA. A crenação artificial não deve ser confundida com poiquilocitose, e uma das formas de diferenciá-la da crenação real é sua presença maciça nos eritrócitos, enquanto a crenação real ou qualquer outra manifestação de poiquilocitose atinge parcialmente as hemácias. Eritrócitos realmente crenados também são chamados de equinócitos e devem-se a distúrbios metabólicos. Eliptócitos
Eliptócitos ou ovalócitos são eritrócitos de formato oval com ou sem área central de palidez, que quando está presente também é oval. Seu significado parece estar relacionado a herança genética que compromete o citoesqueleto das hemácias.
7 Estomatócitos:
Estomatócitos são eritrócitos que apresentam a área central de palidez com o formato de fenda e não arredondada, algumas vezes comparados ao formato de uma boca humana. Estas células ocorrem por defeito na membrana e geralmente estão presentes nas anemias hemolíticas.
Esquistócitos:
Os esquistócitos são hemácias deformadas ou apenas fragmentos destas, que aparecem sob formas diversas. Os esquistócitos são resultado de defeito na produção das hemácias ou destruição acelerada destas, podendo estar presente em processos de vasculite, CID, doenças renais ou esplênicas crônicas e também nas anemias ferroprivas.
Queratócitos:
Os queratócitos são hemácias que apresentam duas protrusões citoplasmáticas que se assemelham a cornos. Em alguns casos, além das projeções, o citoplasma forma uma espécie de arco entre elas; nestes casos, as hemácias são chamadas de vesiculadas.
Dacriócitos:
Dacriócitos são eritrócitos em forma de lágrima ou pera e estão geralmente ligados a problemas na medula óssea ou talassemia.
8 Variação na estrutura dos Eritrócitos:
Inclusões Intra-Eritrocitárias
Os eritrócitos podem apresentar inclusões ou corpúsculos em seu citoplasma que apresentam diferentes formas e significados. As principais inclusões intracitoplasmáticas em eritrócitos são:
- Corpúsculos de Howell-Jolly: são pontos que se coram fortemente, apresentando a cor roxa ou quase preta e geralmente estão na periferia das células. Esses corpúsculos são formados por resquícios de núcleo no citoplasma, por isso denotam a liberação de células jovens na circulação e estão presentes nas anemias regenerativas. Geralmente o baço acaba recolhendo estas células da corrente sanguínea.
- Corpúsculos de Heinz: estes corpúsculos são formados a partir da oxidação da hemoglobina que é vista na forma de projeções pálidas ou refratárias à coloração na periferia dos eritrócitos. Eles surgem após o animal ter recebido algum tipo de sustância oxidante (anemias hemolíticas tóxicas); também podem aparecer em gatos com enteropatias graves causadas por agentes tóxicos e na hemoglobinúria pós-parto das vacas.
- Ponteado basófilo: trata-se da precipitação do RNA citoplasmático formando pontos azuis ao longo da hemácia. Seu significado é o mesmo da policromatofilia, pois indica a presença de um eritrócito jovem. No entanto, um ponteado grosseiro, sem que o animal apresente anemia ou esta seja muito discreta, indica intoxicação por chumbo, chamada saturnismo, mais frequente em cães e seres humanos.
- Inclusões virais: as inclusões virais geralmente aparecem róseas ou azuladas e são de tamanho variável. Além dos eritrócitos, os leucócitos também podem apresentar estas inclusões. No caso da cinomose, as inclusões são chamadas corpúsculos de Sinegaglia-Lentz. Artefatos.
Além da crenação produzida por artefatos conforme citado anteriormente, outras alterações podem ser vistas nos eritrócitos e confundidas com alterações morfológicas verdadeiras. Entre estas alterações ocorrem pontos refratários na superfície das hemácias, provavelmente devido à presença de ar saindo das células ou por colorações fixadas enquanto o esfregaço sanguíneo ainda está úmido (resíduos de água).
Outros artefatos que ocorrem são a presença de precipitados de corante tanto sobre as hemácias como em torno destas, que não devem ser confundidos com hemoparasitos ou inclusões citoplasmáticas. Praticamente todos os artefatos são evitados com a realização adequada das técnicas de coloração.